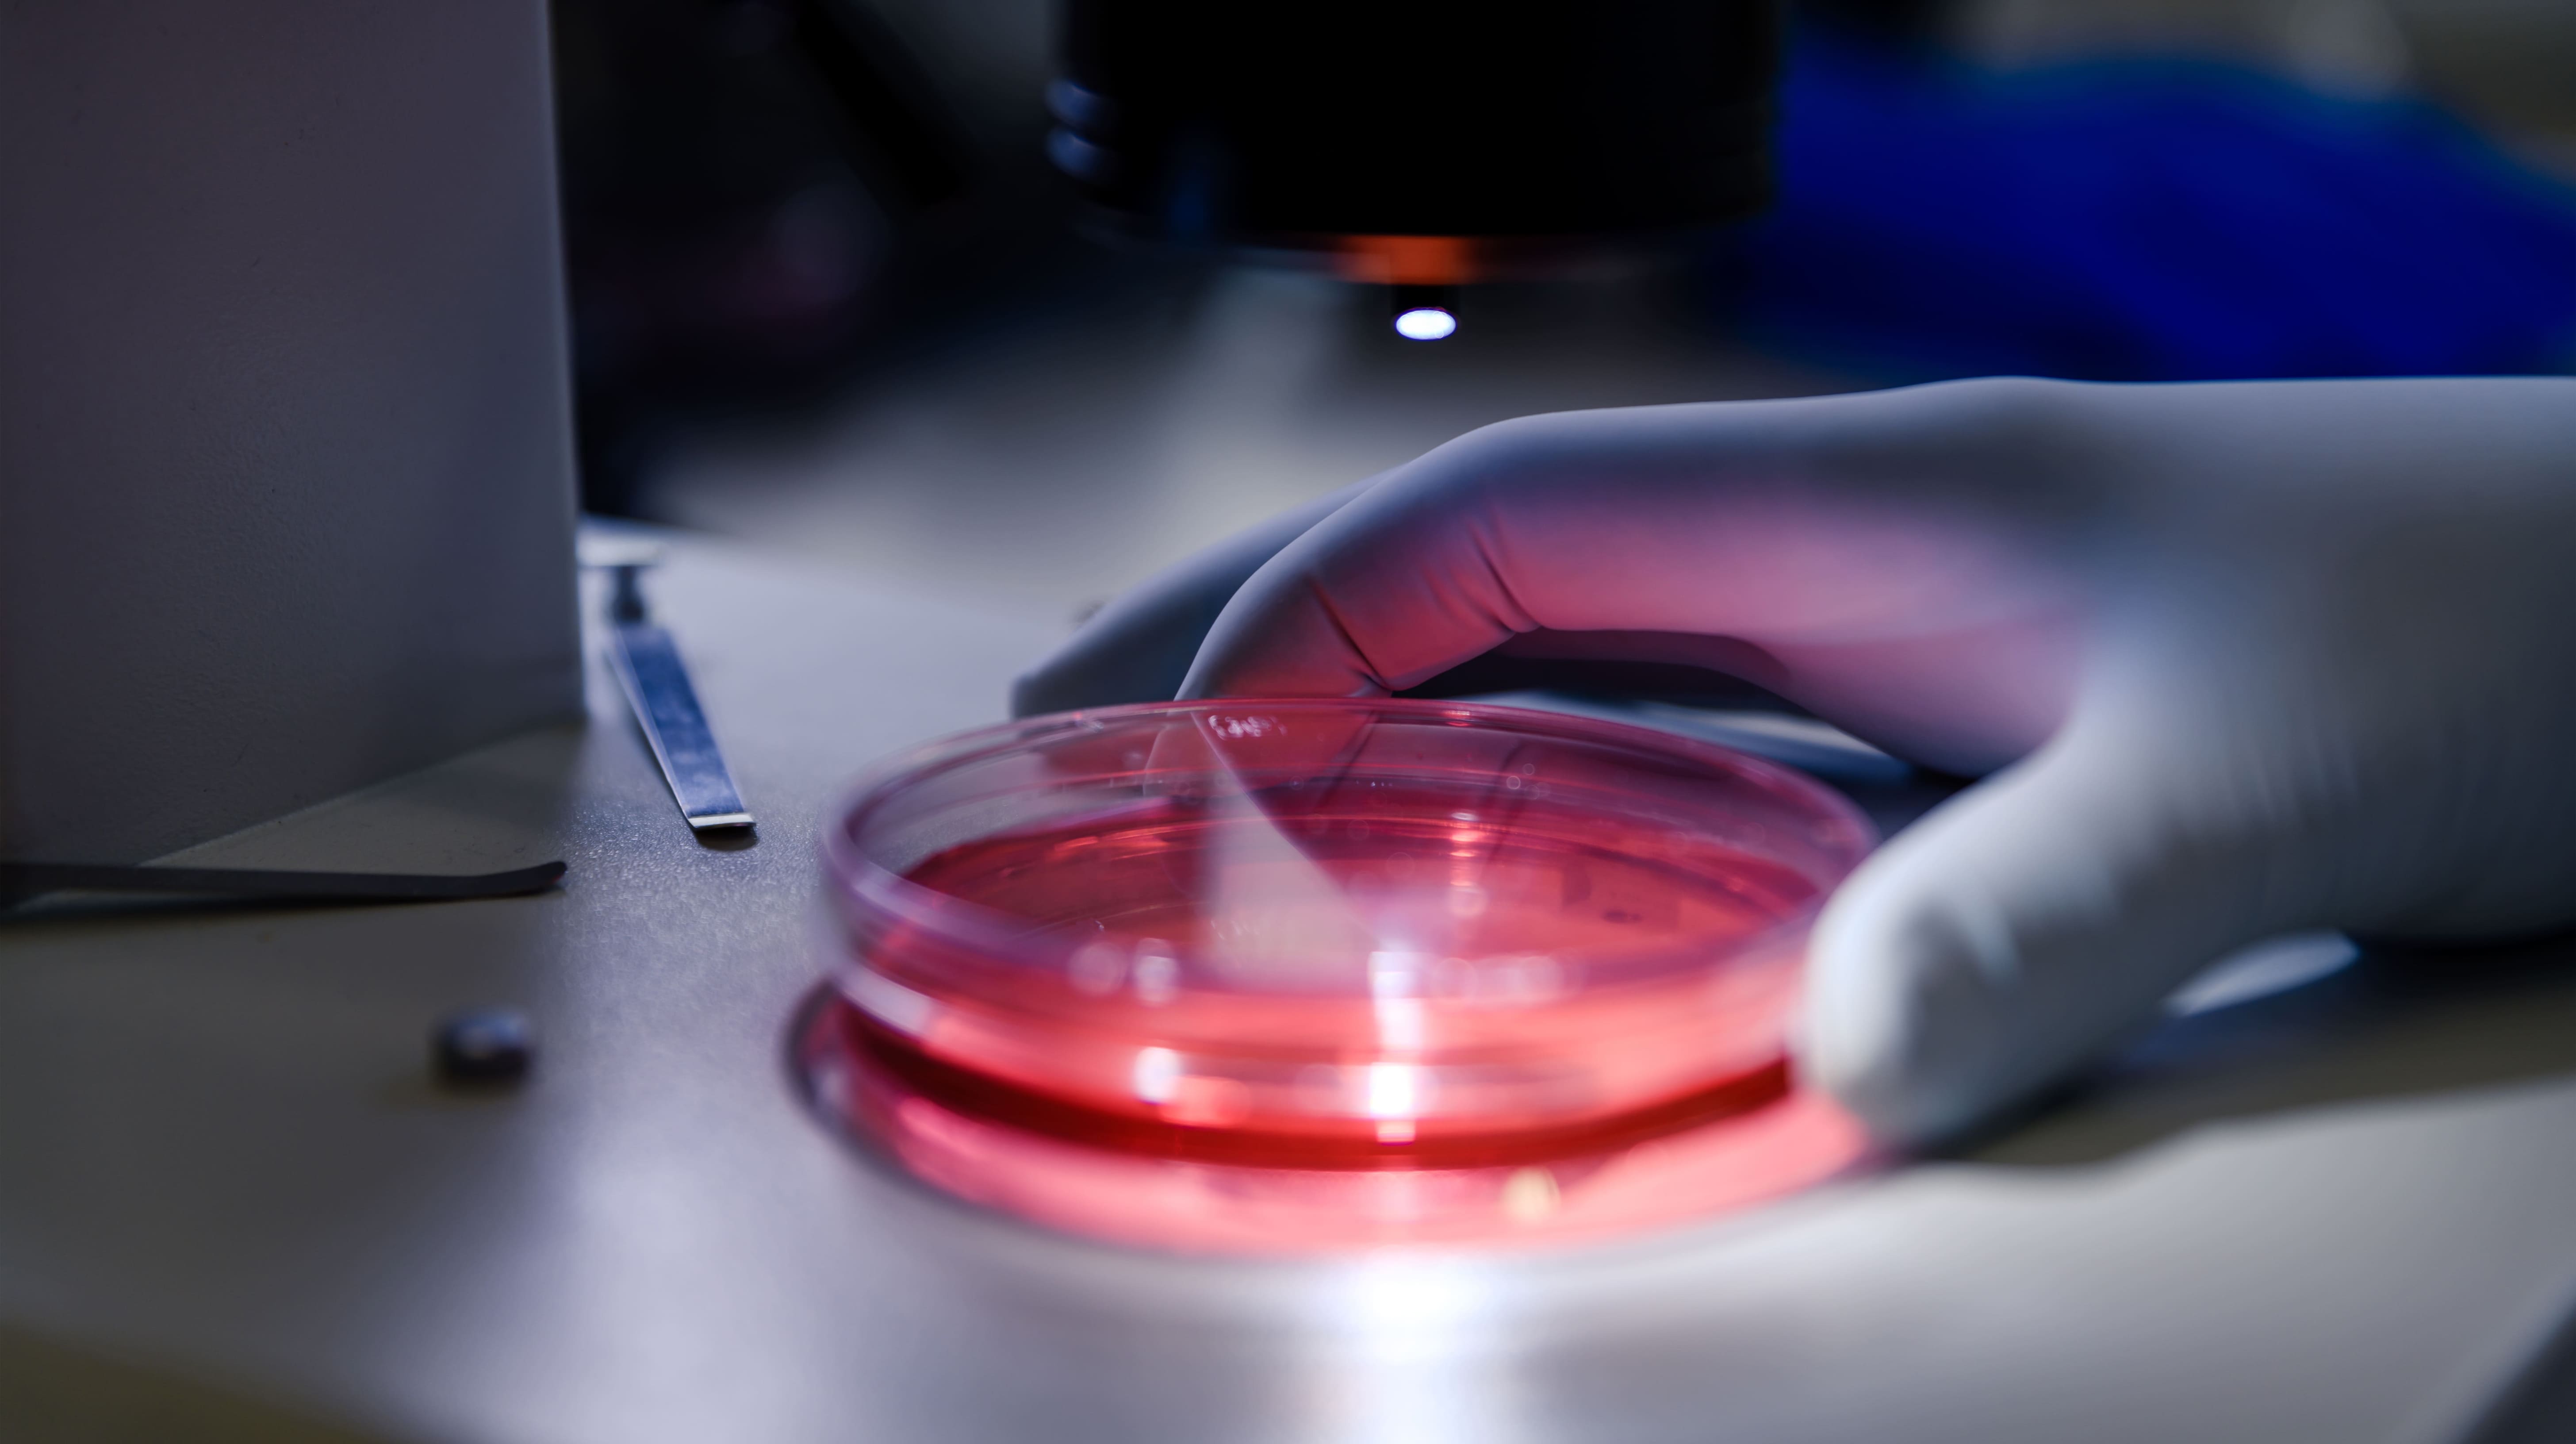

인체제대혈 유래 NK세포배양액과 아스타잔틴이 함유된 크림!
무겁지 않은 산뜻한 크림으로 윤기나는 촉촉한 피부로 가꿔
줍니다. 또한, 흡수가 빠르며 피부를 매끄럽게 케어해줍니다.
50g / 미백∙주름 개선 기능성 화장품

피부 본연의 건강함과 아름다움을 되찾아 주는 특별한 원료.
NK세포배양액은 피부 스스로 생기와 힘을 되찾아, 건강하고
눈부신 피부로 빛날 수 있게 도와줍니다.
※ 제품의 효능이 아닌, 원료의 이해를 돕기 위한 설명입니다.
일반적인 2차원 세포 배양이 아닌, 3차원 입체 세포 배양
기술로 무중력 상태와 유사한 환경에서 세포를 배양합니다.
따라서, 유효성분이 함유된 세포배양액을 효과적으로
얻을 수 있습니다.
※ 제품의 효능이 아닌, 원료의 이해를 돕기 위한 설명입니다.
.jpeg)

아세틸헥사펩타이드-8성분에 SBPP 투과 기술을 적용하여
유효성분의 흡수율을 높인 성분입니다.
ARITOX-B™는 피부깊숙이 빠르게 흡수되어 효과적인
스킨케어를 도와줍니다.
아세틸헥사펩타이드-8성분에 SBPP 투과 기술을 적용하여 유효성분의
흡수율을 높인 성분입니다. ARITOX-B™는 피부깊숙이 빠르게
흡수되어 효과적인 스킨케어를 도와줍니다.
※ 제품의 효능이 아닌, 원료의 이해를 돕기 위한 설명입니다.
프로폴리스 추출물, 병풀 추출물, 연꽃씨 추출물 등 피부 진정에
도움을 주는 8가지 원료를 선별해 만든 추출물 콤플렉스.
조금 민감한 피부에도 마일드한 스킨케어를 제공합니다.
※ 제품의 효능이 아닌, 원료의 이해를 돕기 위한 설명입니다.



리치한 느낌이 적고, 산뜻한 느낌을 주는 핑크 컬러의
텍스처입니다. 흡수가 빨라 끈적임이 적고, 매끄러운
피부결로 가꿔주는 크림입니다.

Step. 1
마이톡스
프로페셔널 링클 앰플
마이톡스
프로페셔널 링클 앰플

Step. 2
마이톡스
프로 에센스
마이톡스
프로페셔널 링클 앰플

Step. 3
마이톡스
리라이트닝 크림

Step. 1
마이톡스
프로페셔널 링클 앰플

Step. 2
마이톡스
프로 에센스

Step. 3
마이톡스
리라이트닝 크림

Step. 1
마이톡스
레드 제이드 마스크
마이톡스
프로페셔널 링클 앰플

Step. 2
마이톡스
프로페셔널 리라이트닝 앰플
마이톡스
프로페셔널 링클 앰플

Step. 3
마이톡스
리라이트닝 크림

Step. 1
마이톡스
레드 제이드 마스크

Step. 2
마이톡스
프로페셔널 리라이트닝 앰플

Step. 3
마이톡스
리라이트닝 크림
현재 스토어 준비중